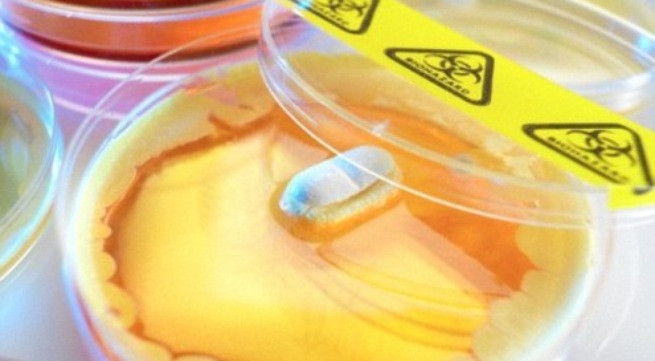
Ảnh minh họa: Internet

Loại thuốc kháng sinh mới có thể chữa được các bệnh nhiễm trùng nguy hiểm và chống lại các mầm bệnh khó tiêu diệt, vốn không đáp ứng với thuốc kháng sinh mạnh. Đặc biệt, đây được xem là vũ khí hiệu quả trong cuộc chiến chống lại hiện tượng kháng thuốc kháng sinh.
Trong bối cảnh không có loại kháng sinh mới tung ra thị trường gần 30 năm qua và vi khuẩn đang ngày càng trở nên khó đối phó, loại siêu kháng sinh này mở ra nhiều hy vọng. Giáo sư Dame Sally Davies, một lãnh đạo trong Bộ Y tế Anh đã mô tả một "kịch bản tận thế" khi các kỹ thuật điều trị phổ biến như thay khớp phải đối mặt với khả năng tử vong lớn vì không thể dập tắt nguy cơ nhiễm trùng.
Loại thuốc có tên Teixobactin được phát hiện khi các nhà khoa học nghiên cứu vi khuẩn tại một đồng cỏ tại Mỹ. Trong các thử nghiệm, những siêu kháng sinh giết chết một loạt các vi khuẩn, bao gồm cả MRSA - loại tụ cầu vàng kháng Methicillin, không đáp ứng điều trị với kháng sinh thông thường, thường gây ra những bệnh nhiễm trùng nghiêm trọng và đe dọa sự sống như nhiễm khuẩn huyết, nhiễm khuẩn vết mổ, viêm phổi...
Teixobactin đặc biệt linh hoạt trong việc chống lại các vi khuẩn dạ dày nguy hiểm và các vi trùng gây hại cho tim. Bệnh lao cũng sẽ trở nên dễ dàng kiểm soát hơn, có thể được điều trị bằng một loại thuốc duy nhất chứ không phải sử dụng hỗn hợp nhiều loại thuốc như hiện nay.
Quan trọng hơn, loại thuốc này không gây tác dụng phụ. Các công ty dược đã bắt tay vào điều chỉnh công thức và hy vọng sẽ bắt đầu thử nghiệm thuốc trên người trong vòng hai năm. Thông thường, các loại vi khuẩn luôn tìm cách biến đổi để kháng lại thuốc kháng sinh. Với Teixobactin, các nhà khoa học tin rằng vi khuẩn sẽ không thể kháng lại trong ít nhất 30 năm tới.
Laura Piddock, giáo sư vi sinh học tại Đại học Birmingham cho biết đột phá này có thể "thay đổi cuộc chơi” và góp phần giải quyết cuộc khủng hoảng kháng sinh hiện nay. Nếu mọi việc suôn sẻ, Teixobactin được sử dụng dưới dạng thuốc tiêm sẽ xuất hiện trên thị trường vào năm 2019.